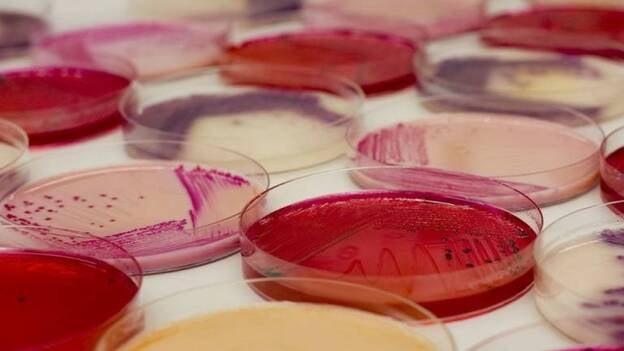
Descubren una gran diversidad de bacterias en las placas solares fotovoltaicas con interés biotecnológico

Secciones
Servicios
- Portadas
- Directorio de empresas
- Gasolineras baratas
- Calendario laboral
- Precio de la luz
- Newsletter
- Esquelas
- Suplementos
- Webcams
- Sorteos Canarias7
- Farmacias de Guardia
- Santoral del día
- Hemeroteca
- El tiempo
- Loterías y Apuestas
- ASINCA
- Colegios Profesionales
- Programación TV
- Cartelera
- Horóscopo
- Espacio C7
Destacamos